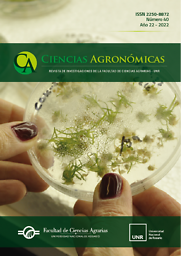
Ciencias agronómicas

Ciencias agronómicas
Accès en ligne
| Accès |
Ressource |
Modalité |
Numéros |
Autres liens |
Action |
| Texte intégral |
Revistas Universidad Nacional de Rosario — Revistas UNR Présentation détaillée de la ressource Revistas Universidad Nacional de Rosario dans Mir@bel |
Libre |
2019 (no 34) — … |
[Dernier numéro] |
 |
Suivi
Cette revue est répertoriée par Mir@bel mais n'est pas encore suivie par un partenaire. La mise à jour des informations n'est pas assurée. Les icônes  et
et  vous permettent de proposer des modifications.
vous permettent de proposer des modifications.
Dernière vérification : 08/12/2025 13:51.
Dernière modification : 03/06/2026 22:14 (titre : mise à jour).

et
et  vous permettent de proposer des modifications.
vous permettent de proposer des modifications.
